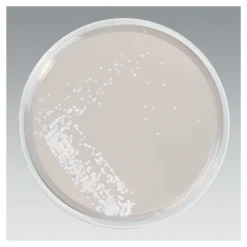
Sabouraud Glucose Nähragar Platten

Zur bakteriologischen Diagnostik von Harnwegsinfektionen.
Agarmedien:
- CLED-Agar Allgemeinnährboden zur Bestimmung der Gesamtkeimzahl.
- MacConkey-Agar unterstützt das Wachstum Gram-negativer Bakterien, abgesehen von Enterokokken, die als stecknadelkopfgroße Kolonien wachsen können.
- Enterokokken-Agar zum Nachweis von Enterokokken Bestimmte Streptokokken der Gruppe B können ebenfalls auf diesem Nährmedium wachsen.